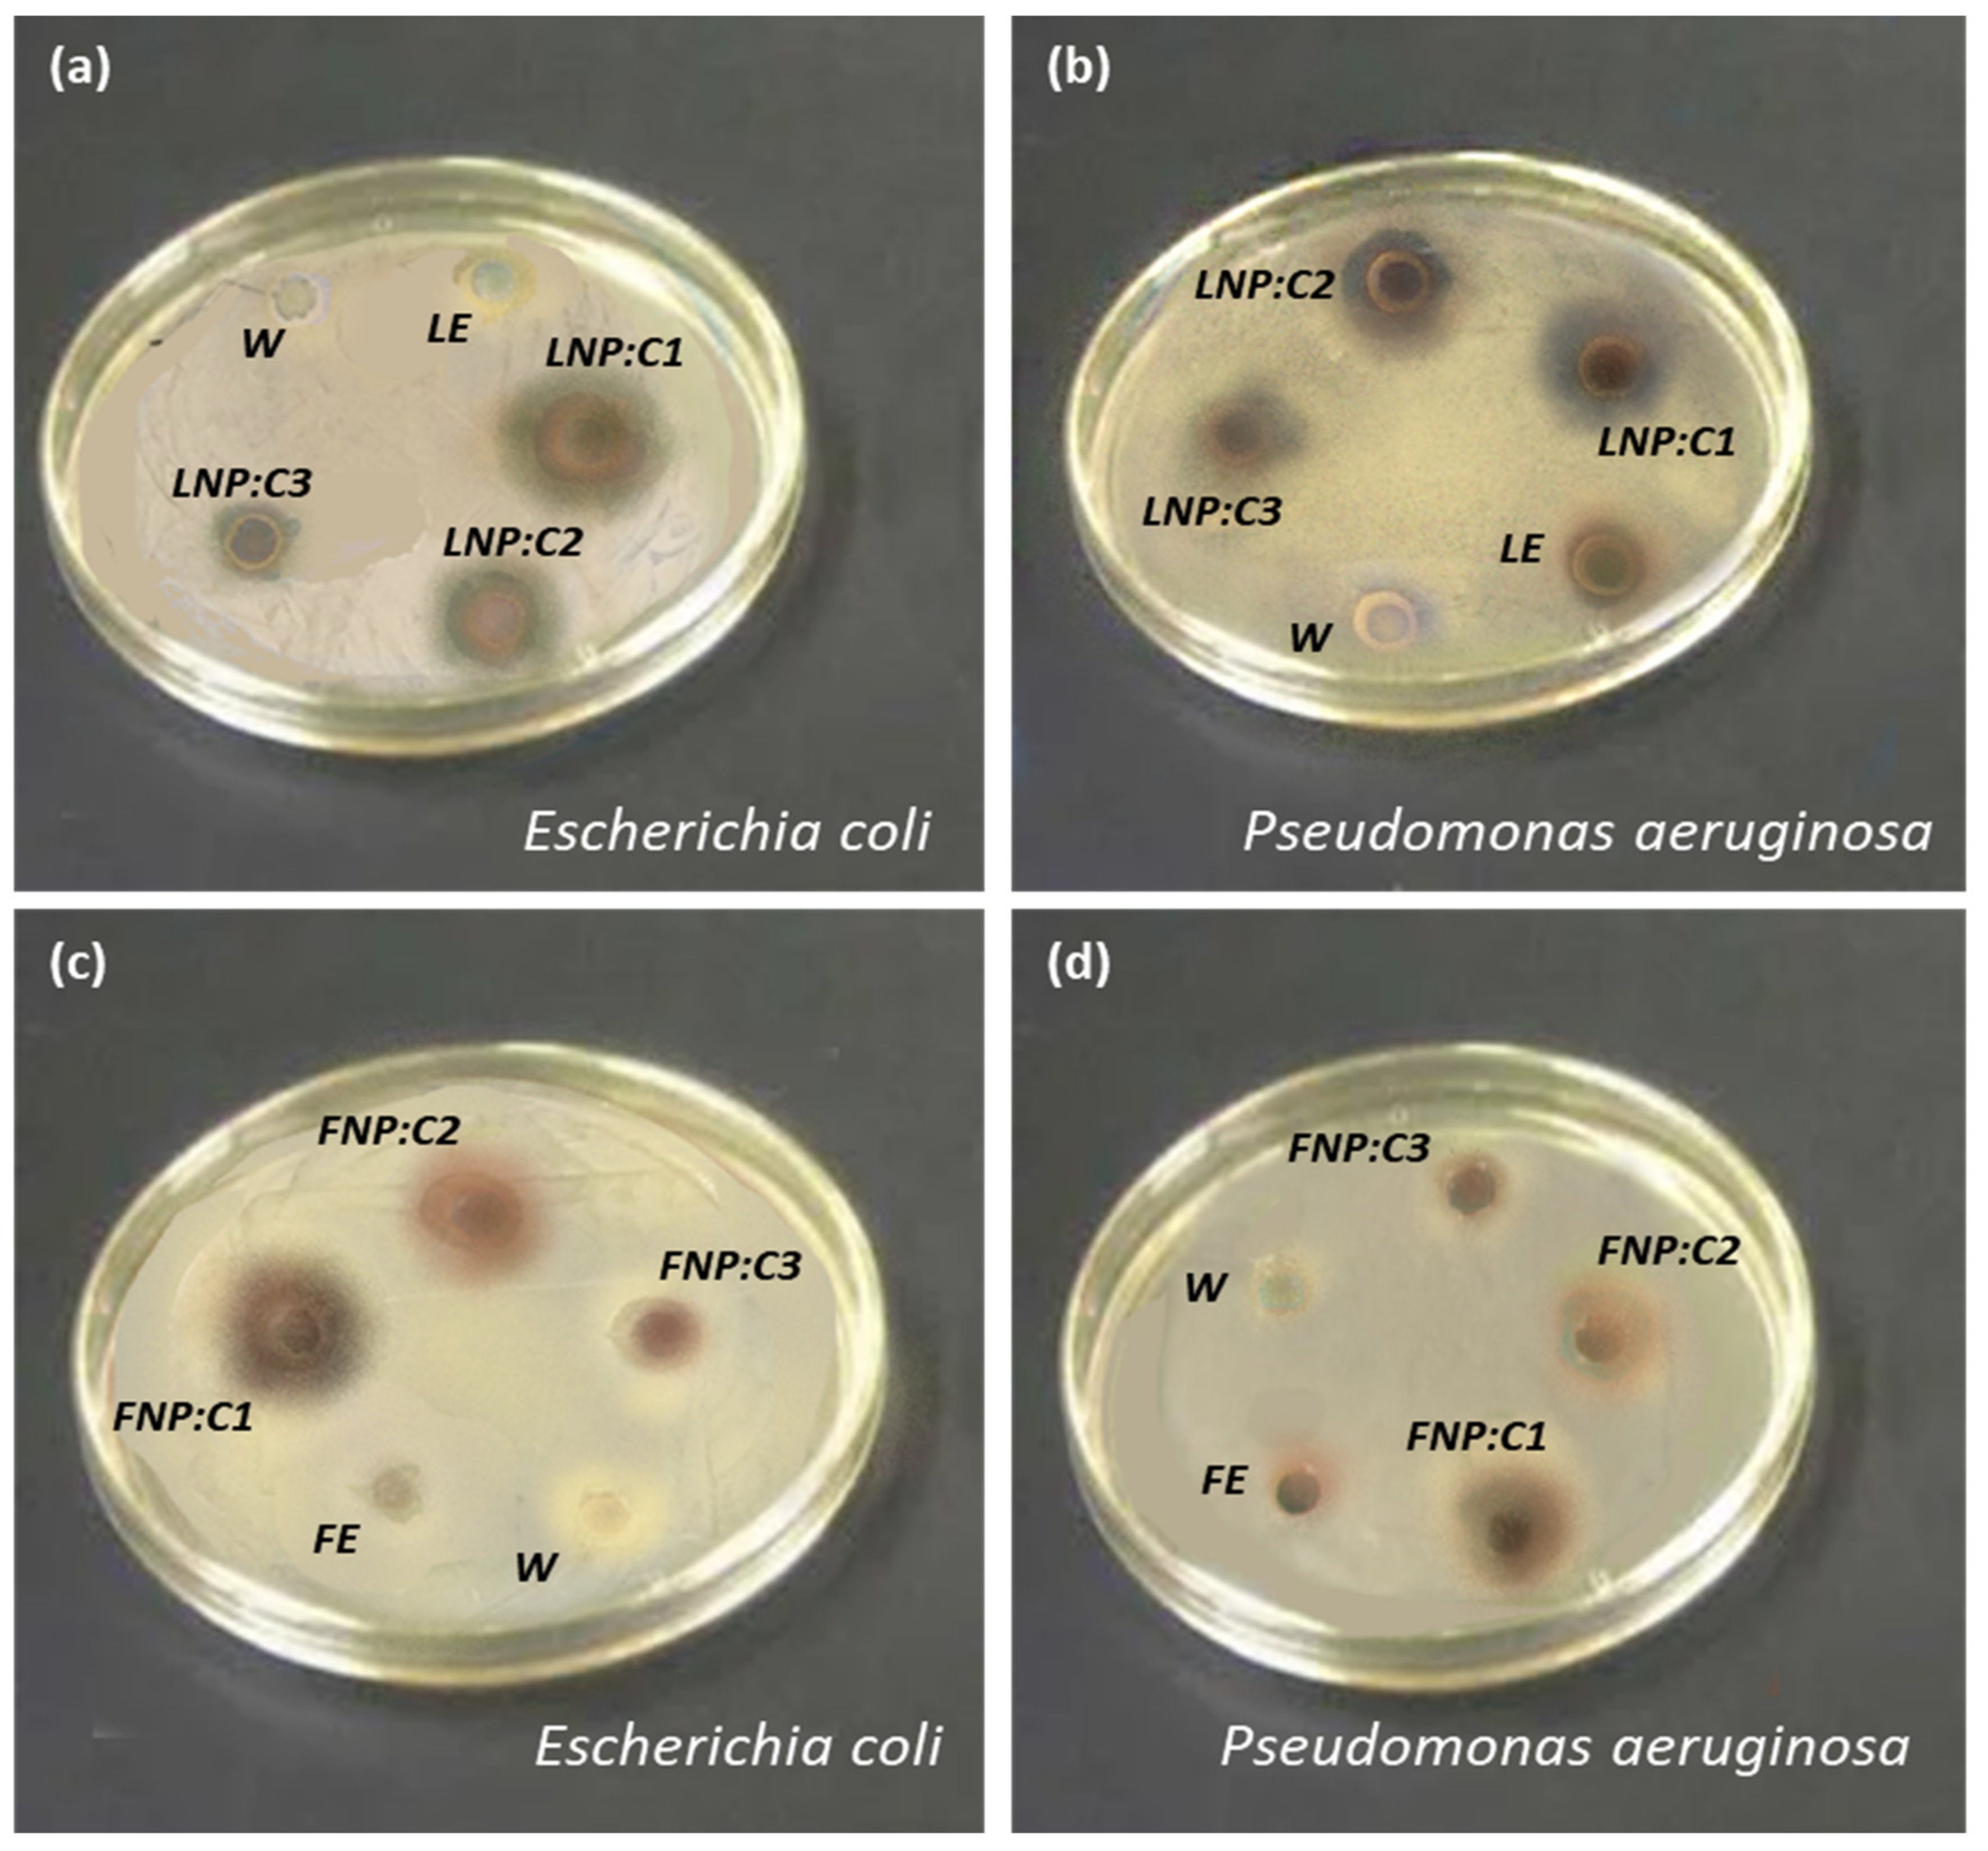
Nanomaterials 12 00616 g008 550

Biosynthesis and Characterizations of Silver Nanoparticles from Annona squamosa Leaf and Fruit Extracts for Size-Dependent Biomedical Applications
Abstract
:1. Introduction
2. Materials and Methods
- Leaf and fruit extract preparation;
- Precursor solution preparation;
- Nanoparticle synthesis.
3. Results and Discussions
3.1. Synthesis of Nanoparticles (NPs)
3.2. Characterizations
3.2.1. X-ray Diffraction (XRD) Analysis
3.2.2. UV-Vis Spectroscopy Analysis
3.2.3. Scanning Electron Microscope (SEM) Analysis
4. Antibacterial Activity
4.1. Antibacterial Activity Results
4.2. Antibacterial Mechanism
5. Conclusions
Author Contributions
Funding
Institutional Review Board Statement
Informed Consent Statement
Data Availability Statement
Acknowledgments
Conflicts of Interest
References
- Rai, M.; Gade, A.; Yadav, A. Biogenic nanoparticles: An introduction to what they are, how they are synthesized and their applications. In Metal Nanoparticles in Microbiology; Springer: Berlin/Heidelberg, Germany, 2011; pp. 1–14. [Google Scholar]
- Christian, P.; Von Der Kammer, F.; Baalousha, M.; Hofmann, T. Nanoparticles: Structure, properties, preparation and behaviour in environmental media. Ecotoxicology 2008, 17, 326–343. [Google Scholar] [CrossRef]
- Shabnam, T.; Behboodi, Z. Comparing green chemical methods and chemical methods for the. Int. J. Pharm. Sci. Res. 2016, 7, 4927–4932. [Google Scholar]
- Naveed Ul Haq, A.; Nadhman, A.; Ullah, I.; Mustafa, G.; Yasinzai, M.; Khan, I. Synthesis Approaches of Zinc Oxide Nanoparticles: The Dilemma of Ecotoxicity. J. Nanomater. 2017, 2017, 8510342. [Google Scholar] [CrossRef]
- Shaikh, A.E.; Satardekar, K.V.; Khan, R.R.; Tarte, N.A.; Barve, S.S. Silver nanoparticles: Green synthesis using Phoenix dactylifera fruit extract, characterization, and anti-oxidant and anti-microbial activities. Appl. Nanosci. 2018, 8, 407–415. [Google Scholar] [CrossRef]
- Li, S.; Shen, Y.; Xie, A.; Yu, X.; Qiu, L.; Zhang, L.; Zhang, Q. Green synthesis of silver nanoparticles using Capsicum annuum L. Extract. Green Chem. 2007, 9, 852–858. [Google Scholar] [CrossRef]
- Bai, H.; Zhang, Z.; Guo, Y.; Jia, W. Biological synthesis of size-controlled cadmium sulfide nanoparticles using immobilized Rhodobacter sphaeroides. Nanoscale Res. Lett. 2009, 4, 717–723. [Google Scholar] [CrossRef] [Green Version]
- Carmona, E.R.; Benito, N.; Plaza, T.; Recio-Sánchez, G. Green synthesis of silver nanoparticles by using leaf extracts from the endemic Buddleja globosa hope. Green Chem. Lett. Rev. 2017, 10, 250–256. [Google Scholar] [CrossRef] [Green Version]
- Sreekanth, T.V.M.; Duk Lee, K. Green Synthesis of Silver Nanoparticles from Carthamus tinctorius Flower Extract and Evaluation of their Antimicrobial and Cytotoxic Activities. Curr. Nanosci. 2012, 7, 1046–1053. [Google Scholar] [CrossRef]
- Burlacu, E.; Tanase, C.; Coman, N.A.; Berta, L. A review of bark-extract-mediated green synthesis of metallic nanoparticles and their applications. Molecules 2019, 24, 4354. [Google Scholar] [CrossRef] [Green Version]
- Tho, N.T.M.; An, T.N.M.; Tri, M.D.; Sreekanth, T.V.M.; Lee, J.-S.; Nagajyothi, P.C.; Lee, K.D. Green synthesis of silver nanoparticles using Nelumbo nucifera seed extract and its antibacterial activity. Acta Chim. Slov. 2013, 60, 673–678. [Google Scholar]
- Sathyavathi, R.; Bala Murali Krishna, M.; Narayana Rao, D. Biosynthesis of silver nanoparticles using Moringa oleifera leaf extract and its application to optical limiting. J. Nanosci. Nanotechnol. 2011, 11, 2031–2035. [Google Scholar] [CrossRef]
- Lalithamba, H.S.; Raghavendra, M.; Uma, K.; Yatish, K.V.; Mousumi, D.; Nagendra, G. Capsicum annuum fruit extract: A novel reducing agent for the green synthesis of ZnO nanoparticles and their multifunctional applications. Acta Chim. Slov. 2018, 65, 354–364. [Google Scholar] [CrossRef]
- Al-Radadi, N.S. Green synthesis of platinum nanoparticles using Saudi’s Dates extract and their usage on the cancer cell treatment. Arab. J. Chem. 2019, 12, 330–349. [Google Scholar] [CrossRef]
- Rauwel, P.; Küünal, S.; Ferdov, S.; Rauwel, E. A review on the green synthesis of silver nanoparticles and their morphologies studied via TEM. Adv. Mater. Sci. Eng. 2015, 2015. [Google Scholar] [CrossRef] [Green Version]
- Kakakhel, M.A.; Saif, I.; Ullah, N.; Faisal, S.; Anwar, Z.; Zaheer Ud Din, S. Waste fruit peel mediated synthesis of silver nanoparticles and its antibacterial activity. BioNanoScience 2021, 11, 469–475. [Google Scholar] [CrossRef]
- Kalyani, R.L.; Vijaykumar, P.P.N.; Pammi, S.V.N.; Rajkumar, M.; Swamy, P.V.; Murthy, K.V.R. Biosynthesis of silver nanoparticles using Annona squamosa leaf extract with synergistic antibacterial activity. Indian J. Pharm. Sci. 2019, 81, 1036–1044. [Google Scholar] [CrossRef]
- Mathew, L.; Chandrasekaran, N.; Mukherjee, A. Biomimetic Synthesis of Nanoparticles: Science, Technology & Applicability; Books on Demand: Norderstedt, Germany, 2010. [Google Scholar]
- Ahmad, N.; Sharma, S.; Alam, M.K.; Singh, V.N.; Shamsi, S.F.; Mehta, B.R.; Fatma, A. Rapid synthesis of silver nanoparticles using dried medicinal plant of basil. Colloids Surf. B Biointerfaces 2010, 81, 81–86. [Google Scholar] [CrossRef]
- Panigrahi, S.; Kundu, S.; Ghosh, S.; Nath, S.; Pal, T. General method of synthesis for metal nanoparticles. J. Nanoparticle Res. 2004, 6, 411–414. [Google Scholar] [CrossRef]
- Ishak, N.A.I.M.; Kamarudin, S.K.; Timmiati, S.N. Green synthesis of metal and metal oxide nanoparticles via plant extracts: An overview. Mater. Res. Express 2019, 6, 112004. [Google Scholar] [CrossRef]
- Pandey, N.; Barve, D. Phytochemical and pharmacological review on Annona squamosa Linn. Int. J. Res. Pharm. Biomed. Sci. 2011, 2, 1404–1412. [Google Scholar]
- Yu, J.G.; Luo, X.Z.; Sun, L.; Li, D.Y.; Huang, W.H.; Liu, C.Y. Chemical constituents from the seeds of Annona squamosa. Yao Xue Xue Bao Acta Pharm. Sin. 2005, 40, 153–158. [Google Scholar]
- Anand David, A.V.; Arulmoli, R.; Parasuraman, S. Overviews of biological importance of quercetin: A bioactive flavonoid. Pharmacogn. Rev. 2016, 10, 84–89. [Google Scholar]
- Lee, S.H.; Jun, B.H. Silver nanoparticles: Synthesis and application for nanomedicine. Int. J. Mol. Sci. 2019, 20, 865. [Google Scholar] [CrossRef] [Green Version]
- Neelu, C. Silver nanoparticles: Synthesis, characterization and applications. In Silver Nanoparticles: Fabrication, Characterization and Applications; IntechOpen: London, UK, 2018. [Google Scholar] [CrossRef]
- Krishnaraj, C.; Jagan, E.G.; Rajasekar, S.; Selvakumar, P.; Kalaichelvan, P.T.; Mohan, N. Synthesis of silver nanoparticles using Acalypha indica leaf extracts and its antibacterial activity against water borne pathogens. Colloids Surf. B Biointerfaces 2010, 76, 50–56. [Google Scholar] [CrossRef]
- Sorescu, A.-A.; Nuţă, A.; Rodica, M.; Bunghez, I. Green synthesis of silver nanoparticles using plant extracts. In Proceedings of the 4th International Virtual Conference on Advanced Scientific Results, Virtual Conference, 6–10 June 2016; pp. 10–16. [Google Scholar]
- Okafor, F.; Janen, A.; Kukhtareva, T.; Edwards, V.; Curley, M. Green synthesis of silver nanoparticles, their characterization, application and antibacterial activity. Int. J. Environ. Res. Public Health 2013, 10, 5221–5238. [Google Scholar] [CrossRef] [Green Version]
- Yasir, M.; Singh, J.; Tripathi, M.K.; Singh, P.; Shrivastava, R. Green synthesis of silver nanoparticles using leaf extract of common arrowhead houseplant and its anticandidal activity. Pharmacogn. Mag. 2017, 13, S840–S844. [Google Scholar]
- Iravani, S. Green synthesis of metal nanoparticles using plants. Green Chem. 2011, 13, 2638–2650. [Google Scholar] [CrossRef]
- Yusof, K.N.; Alias, S.S.; Harun, Z.; Basri, H.; Azhar, F.H. Parkia speciosa as Reduction Agent in Green Synthesis Silver Nanoparticles. ChemistrySelect 2018, 3, 8881–8885. [Google Scholar] [CrossRef]
- Johnson, I.; Prabu, H.J. Green synthesis and characterization of silver nanoparticles by leaf extracts of Cycas circinalis, Ficus amplissima, Commelina benghalensis and Lippia nodiflora. Int. Nano Lett. 2015, 5, 43–51. [Google Scholar] [CrossRef] [Green Version]
- Sujitha, V.; Murugan, K.; Paulpandi, M.; Panneerselvam, C.; Suresh, U.; Roni, M.; Nicoletti, M.; Higuchi, A.; Madhiyazhagan, P.; Subramaniam, J.; et al. Green-synthesized silver nanoparticles as a novel control tool against dengue virus (DEN-2) and its primary vector Aedes aegypti. Parasitol. Res. 2015, 114, 3315–3325. [Google Scholar] [CrossRef] [PubMed]
- Azhar, M.F.H. Mixed Matrix Polymer Membrane Incorporated with Biosynthesize Additive for Water Separation Process. Ph.D. Thesis, Universiti Tun Hussein Onn Malaysia, Batu Pahat, Malaysia, 2016. [Google Scholar]
- Bunaciu, A.A.; UdriŞTioiu, E.G.; Aboul-Enein, H.Y. X-ray diffraction: Instrumentation and applications. Crit. Rev. Anal. Chem. 2015, 45, 289–299. [Google Scholar] [CrossRef]
- Rajeshkumar, S.; Bharath, L.V. Mechanism of plant-mediated synthesis of silver nanoparticles—A review on biomolecules involved, characterization and antibacterial activity. Chem. Biol. Interact. 2017, 273, 219–227. [Google Scholar] [CrossRef]
- Barbara, L.D.; Christine, M.C. X-ray Powder Diffraction (XRD). Available online: https://serc.carleton.edu/research_education/geochemsheets/techniques/XRD (accessed on 18 September 2021).
- Mehta, B.K.; Chhajlani, M.; Shrivastava, B.D. Green synthesis of silver nanoparticles and their characterization by XRD. J. Phys. 2017, 836, 12050. [Google Scholar] [CrossRef] [Green Version]
- Jauncey, G.E.M. The scattering of X-rays and Bragg’s law. Proc. Natl. Acad. Sci. USA 1924, 10, 57. [Google Scholar] [CrossRef] [Green Version]
- Holzwarth, U.; Gibson, N. The Scherrer equation versus the ‘Debye-Scherrer equation’. Nat. Nanotechnol. 2011, 6, 534. [Google Scholar] [CrossRef]
- Amendola, V.; Bakr, O.M.; Stellacci, F. A study of the surface plasmon resonance of silver nanoparticles by the discrete dipole approximation method: Effect of shape, size, structure, and assembly. Plasmonics 2010, 5, 85–97. [Google Scholar] [CrossRef]
- Westcott, S.L.; Oldenburg, S.J.; Lee, T.R.; Halas, N.J. Formation and adsorption of clusters of gold nanoparticles onto functionalized silica nanoparticle surfaces. Langmuir 1998, 14, 5396–5401. [Google Scholar] [CrossRef]
- Ashraf, J.M.; Ansari, M.A.; Khan, H.M.; Alzohairy, M.A.; Choi, I. Green synthesis of silver nanoparticles and characterization of their inhibitory effects on AGEs formation using biophysical techniques. Sci. Rep. 2016, 6, 1–10. [Google Scholar] [CrossRef] [Green Version]
- Raza, M.A.; Kanwal, Z.; Rauf, A.; Sabri, A.N.; Riaz, S.; Naseem, S. Size- and shape-dependent antibacterial studies of silver nanoparticles synthesized by wet chemical routes. Nanomaterials 2016, 6, 74. [Google Scholar] [CrossRef] [Green Version]
- Feng, Y.; Lin, S.; Huang, S.; Shrestha, S.; Conibeer, G. Can Tauc plot extrapolation be used for direct-band-gap semiconductor nanocrystals? J. Appl. Phys. 2015, 117, 125701. [Google Scholar] [CrossRef]
- Thirumagal, N.; Jeyakumari, A.P. Structural, Optical and Antibacterial Properties of Green Synthesized Silver Nanoparticles (AgNPs) Using Justicia adhatoda L. Leaf Extract. J. Clust. Sci. 2020, 31, 487–497. [Google Scholar] [CrossRef]
- Abdalameer, N.K.; Khalaph, K.A.; Ali, E.M. Ag/AgO nanoparticles: Green synthesis and investigation of their bacterial inhibition effects. Mater. Today Proc. 2021, 45, 5788–5792. [Google Scholar] [CrossRef]
- Das, A.J.; Kumar, R.; Goutam, S.P. Sunlight Irradiation Induced Synthesis of Silver Nanoparticles using Glycolipid Bio-surfactant and Exploring the Antibacterial Activity. J. Bioeng. Biomed. Sci. 2016, 6, 5. [Google Scholar] [CrossRef]
- Srirangam, G.M.; Parameswara Rao, K. Synthesis and charcterization of silver nanoparticles from the leaf extract of Malachra capitata (L.). Rasayan J. Chem. 2017, 10, 46–53. [Google Scholar]
- Fissan, H.; Ristig, S.; Kaminski, H.; Asbach, C.; Epple, M. Comparison of different characterization methods for nanoparticle dispersions before and after aerosolization. Anal. Methods 2014, 6, 7324–7334. [Google Scholar] [CrossRef] [Green Version]
- Dada, A.O.; Adekola, F.A.; Adeyemi, O.S.; Bello, O.M.; Oluwaseun, A.C.; Awakan, O.J.; Grace, F.-A.A. Exploring the Effect of Operational Factors and Characterization Imperative to the Synthesis of Silver Nanoparticles. In Silver Nanoparticles: Fabrication, Characterization and Applications; IntechOpen: London, UK, 2018. [Google Scholar] [CrossRef] [Green Version]
- Mehmood, A.; Murtaza, G.; Bhatti, T.M.; Kausar, R. Phyto-mediated synthesis of silver nanoparticles from Melia azedarach L. leaf extract: Characterization and antibacterial activity. Arab. J. Chem. 2017, 10, S3048–S3053. [Google Scholar] [CrossRef] [Green Version]
- Rasool, S.; Raza, M.A.; Manzoor, F.; Kanwal, Z.; Riaz, S.; Iqbal, M.J.; Naseem, S. Biosynthesis, characterization and anti-dengue vector activity of silver nanoparticles prepared from Azadirachta indica and Citrullus colocynthis: Biosynthesis of silver nanoparticles. R. Soc. Open Sci. 2020, 7, 200540. [Google Scholar] [CrossRef]
- Prabhu, S.; Poulose, E.K. Silver nanoparticles: Mechanism of antimicrobial action, synthesis, medical applications, and toxicity effects. Int. Nano Lett. 2012, 2, 1–10. [Google Scholar] [CrossRef] [Green Version]
- Klueh, U.; Wagner, V.; Kelly, S.; Johnson, A.; Bryers, J.D. Efficacy of silver-coated fabric to prevent bacterial colonization and subsequent device-based biofilm formation. J. Biomed. Mater. Res. Off. J. Soc. Biomater. Jpn. Soc. Biomater. Aust. Soc. Biomater. Korean Soc. Biomater. 2000, 53, 621–631. [Google Scholar] [CrossRef]
- Dibrov, P.; Dzioba, J.; Gosink, K.K.; Haäse, C.C. Chemiosmotic mechanism of antimicrobial activity of Ag+ in Vibrio cholerae. Antimicrob. Agents Chemother. 2002, 46, 2668–2670. [Google Scholar] [CrossRef] [Green Version]
- Niño-Martínez, N.; Salas Orozco, M.F.; Martínez-Castañón, G.-A.; Torres Méndez, F.; Ruiz, F. Molecular mechanisms of bacterial resistance to metal and metal oxide nanoparticles. Int. J. Mol. Sci. 2019, 20, 2808. [Google Scholar] [CrossRef] [PubMed] [Green Version]

| Sample | Two Theta (2θ) (Degrees) | FWHM β (Rad) | Miller INDICES | Lattice Constant (nm) | Crystallite Size (nm) |
|---|---|---|---|---|---|
| Annona squamosa leaf extract mediated AgNPs | 37.5° | 0.0069 | (111) | 1.34 | 21.4 |
| Annona squamosa fruit extract mediated AgNPs | 38.2° | 0.0197 | (111) | 0.539 | 8.0 |
| Samples | Concentration of Nanoparticles | Zone of Inhibition (ZOI) | |
|---|---|---|---|
| E. coli | P. aeruginosa | ||
| Annona squamosa leaf extract-mediated Silver Nanoparticles | 100 µg/mL | 19.3 mm | 18.8 mm |
| 50 µg/mL | 16.5 mm | 16.1 mm | |
| 25 µg/mL | 15.7 mm | 14.6 mm | |
| Annona squamosa fruit extract-mediated Silver Nanoparticles | 100 µg/mL | 16.2 mm | 16.8 mm |
| 50 µg/mL | 15.4 mm | 16.0 mm | |
| 25 µg/mL | 13.6 mm | 14.8 mm | |
Publisher’s Note: MDPI stays neutral with regard to jurisdictional claims in published maps and institutional affiliations. |
© 2022 by the authors. Licensee MDPI, Basel, Switzerland. This article is an open access article distributed under the terms and conditions of the Creative Commons Attribution (CC BY) license (https://creativecommons.org/licenses/by/4.0/).
Share and Cite
Malik, M.; Iqbal, M.A.; Malik, M.; Raza, M.A.; Shahid, W.; Choi, J.R.; Pham, P.V. Biosynthesis and Characterizations of Silver Nanoparticles from Annona squamosa Leaf and Fruit Extracts for Size-Dependent Biomedical Applications. Nanomaterials 2022, 12, 616. https://doi.org/10.3390/nano12040616
Malik M, Iqbal MA, Malik M, Raza MA, Shahid W, Choi JR, Pham PV. Biosynthesis and Characterizations of Silver Nanoparticles from Annona squamosa Leaf and Fruit Extracts for Size-Dependent Biomedical Applications. Nanomaterials. 2022; 12(4):616. https://doi.org/10.3390/nano12040616
Chicago/Turabian StyleMalik, Maria, Muhammad Aamir Iqbal, Mariam Malik, Muhammad Akram Raza, Wajeehah Shahid, Jeong Ryeol Choi, and Phuong V. Pham. 2022. "Biosynthesis and Characterizations of Silver Nanoparticles from Annona squamosa Leaf and Fruit Extracts for Size-Dependent Biomedical Applications" Nanomaterials 12, no. 4: 616. https://doi.org/10.3390/nano12040616
APA StyleMalik, M., Iqbal, M. A., Malik, M., Raza, M. A., Shahid, W., Choi, J. R., & Pham, P. V. (2022). Biosynthesis and Characterizations of Silver Nanoparticles from Annona squamosa Leaf and Fruit Extracts for Size-Dependent Biomedical Applications. Nanomaterials, 12(4), 616. https://doi.org/10.3390/nano12040616

